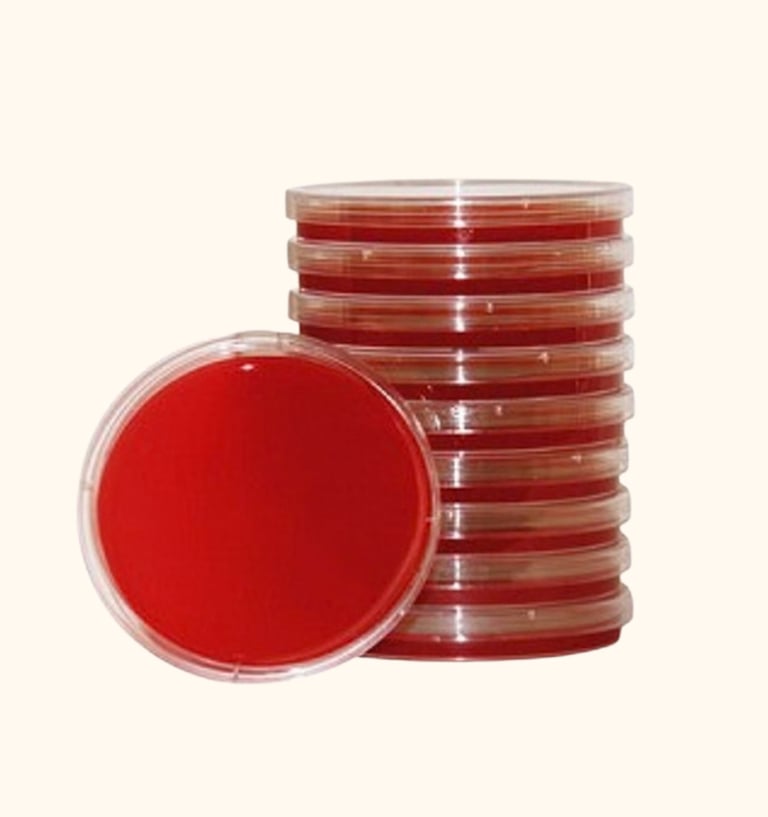
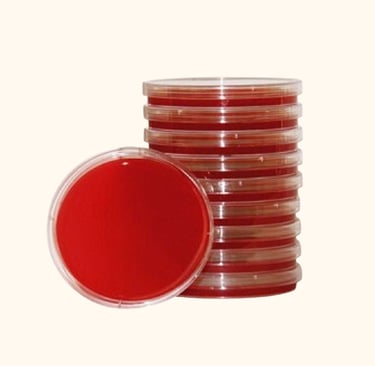
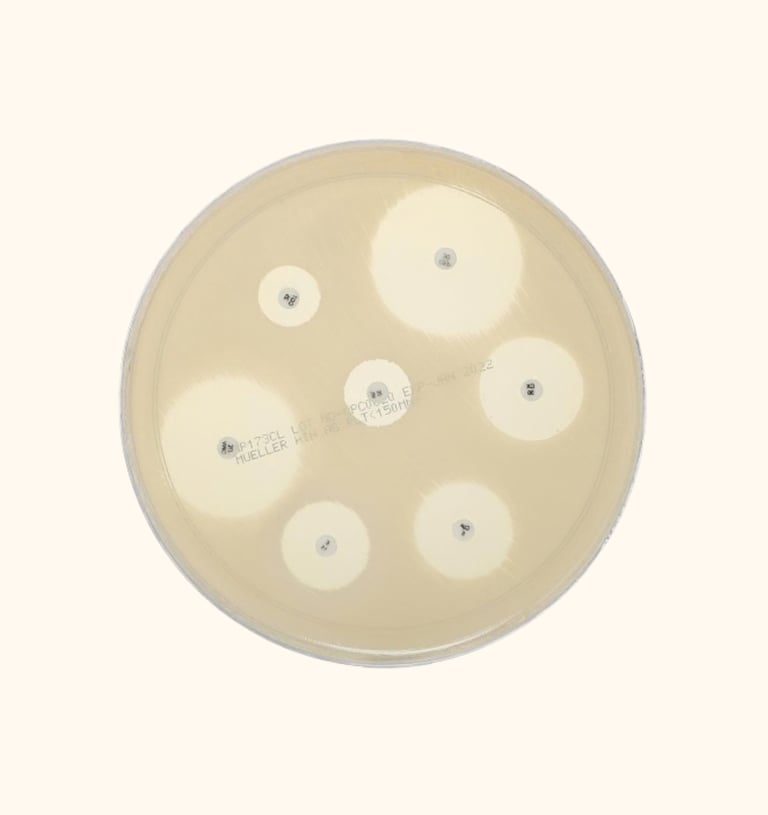
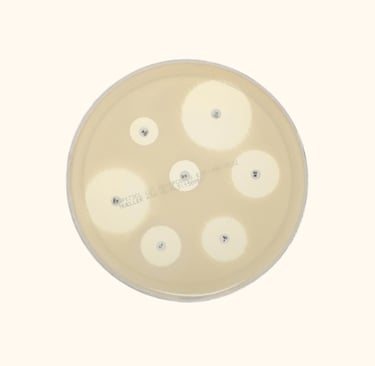

Microbiology
Provide a short description of categories listed below.
Blood Agar Media

Nutrient Agar
Mueller Hinton Agar


Antibiotic Discs
Request a Free Quotation
Please Fill up the below form and hit the submit button to get a free quotation.
Our expert will reach out to you as soon as possible!!